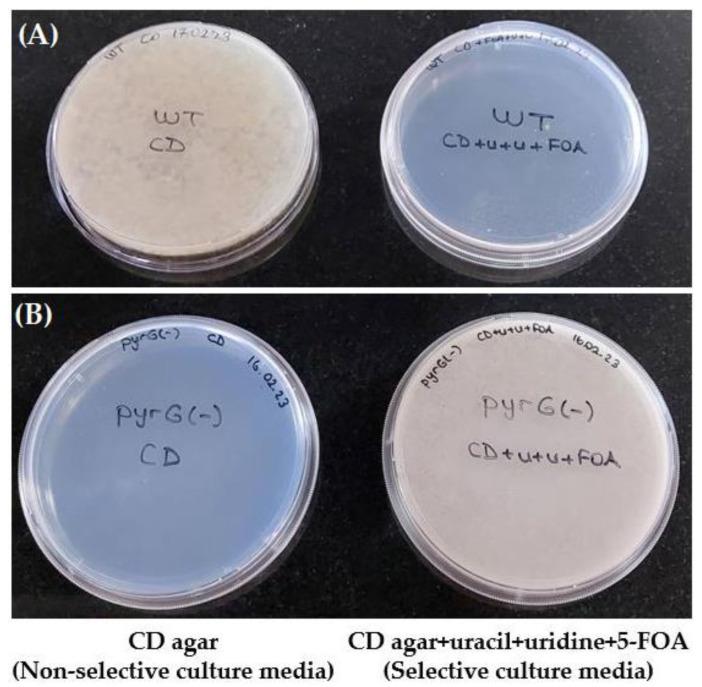
https://cdn.ncbi.nlm.nih.gov/pmc/blobs/f01e/10297652/c3dff5644518/cimb-45-00304-g003.jpg

在营养缺陷型中表达的抗核糖核酸酶A VHH的大规模生产
Large-Scale Production of Anti-RNase A VHH Expressed in Auxotrophic .
作者信息
Karaman Elif, Eyüpoğlu Alp Ertunga, Mahmoudi Azar Lena, Uysal Serdar
机构信息
Beykoz Institute of Life Sciences and Biotechnology, Bezmialem Vakif University, 34820 Istanbul, Turkey.
Department of Biotechnology, Institute of Health Sciences, Bezmialem Vakif University, 34093 Istanbul, Turkey.
出版信息
Curr Issues Mol Biol. 2023 May 31;45(6):4778-4795. doi: 10.3390/cimb45060304.
Nanobodies, also referred to as VHH antibodies, are the smallest fragments of naturally produced camelid antibodies and are ideal affinity reagents due to their remarkable properties. They are considered an alternative to monoclonal antibodies (mAbs) with potential utility in imaging, diagnostic, and other biotechnological applications given the difficulties associated with mAb expression. is a potential system for the large-scale expression and production of functional VHH antibodies that can be used to meet the demand for affinity reagents. In this study, anti-RNase A VHH was expressed under the control of the glucoamylase promoter in auxotrophic grown in a fermenter. The feature of auxotrophy, selected for the construction of a stable and efficient platform, was established using homologous recombination. Pull-down assay, size exclusion chromatography, and surface plasmon resonance were used to confirm the binding specificity of anti-RNase A VHH to RNase A. The affinity of anti-RNase A VHH was nearly 18.3-fold higher (1.9 nM) when expressed in auxotrophic rather than in . This demonstrates that auxotrophic is a practical, industrially scalable, and promising biotechnological platform for the large-scale production of functional VHH antibodies with high binding activity.
纳米抗体,也被称为VHH抗体,是天然产生的骆驼科动物抗体的最小片段,由于其卓越的特性,是理想的亲和试剂。鉴于单克隆抗体(mAb)表达存在困难,它们被认为是单克隆抗体的替代品,在成像、诊断和其他生物技术应用中具有潜在用途。是一个用于大规模表达和生产功能性VHH抗体的潜在系统,可用于满足对亲和试剂的需求。在本研究中,抗核糖核酸酶A VHH在糖化酶启动子的控制下,在发酵罐中培养的营养缺陷型中表达。利用同源重组建立了用于构建稳定高效平台的营养缺陷型特征。采用下拉试验、尺寸排阻色谱和表面等离子体共振来确认抗核糖核酸酶A VHH与核糖核酸酶A的结合特异性。当在营养缺陷型中表达时,抗核糖核酸酶A VHH的亲和力比在中表达时高近18.3倍(1.9 nM)。这表明营养缺陷型是一个实用的、可工业扩展的、有前景的生物技术平台,可用于大规模生产具有高结合活性的功能性VHH抗体。